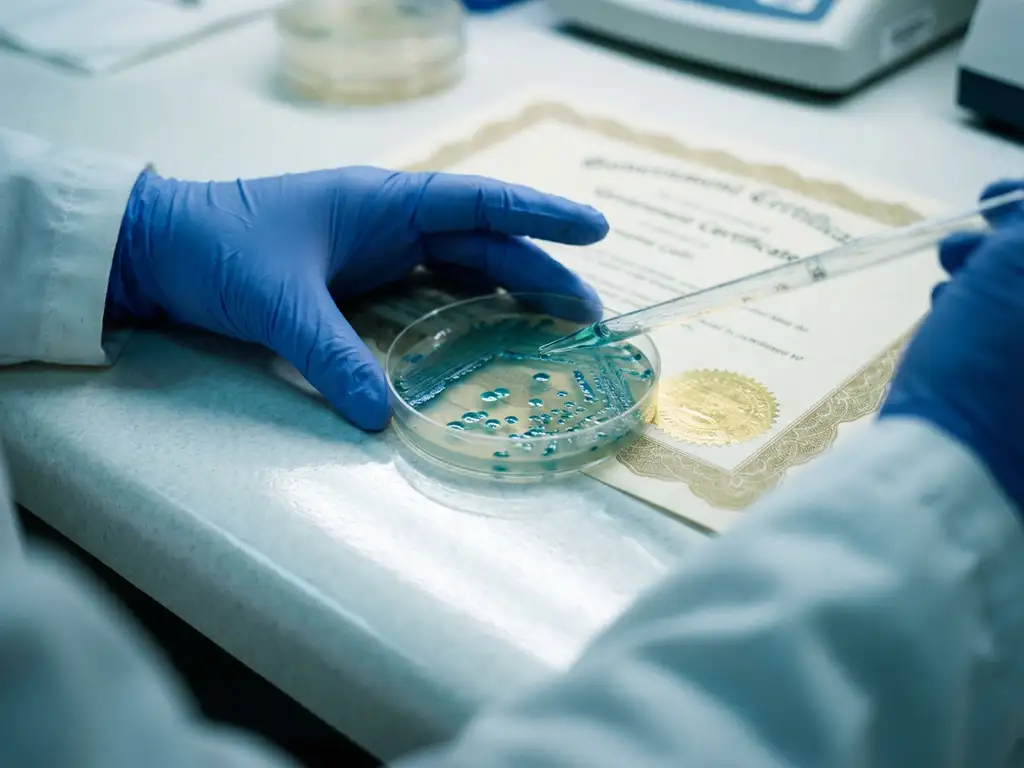
Scientist in latex gloves using pipette over petri dish with teal bacterial colonies on laboratory countertop

Regulatory requirements for gut microbiome testing encompass multiple frameworks across different product categories and jurisdictions. The FDA, EFSA, and Health Canada each maintain specific guidelines for microbiome research methodologies, testing protocols, and product development pathways. Requirements vary significantly between research-grade testing and clinical diagnostic applications, with distinct documentation standards for preclinical studies versus human trials.
What regulatory frameworks govern gut microbiome testing and research?
Three primary regulatory bodies oversee gut microbiome testing: the FDA in the United States, EFSA in Europe, and Health Canada. Each maintains distinct guidelines for microbiome research methodologies, testing protocols, and product development pathways that companies must navigate based on their target markets.
The FDA regulates microbiome testing under different frameworks depending on the intended use. Research-grade testing falls under laboratory-developed test guidelines, while clinical diagnostic applications require more stringent validation under the Clinical Laboratory Improvement Amendments (CLIA). The agency distinguishes between investigational use and commercial diagnostic applications, with each requiring different levels of analytical and clinical validation.
EFSA focuses heavily on mechanistic evidence for health-claim substantiation. Its guidance emphasises the need for robust mode-of-action data that demonstrate biological plausibility. Testing methodologies must show clear cause-and-effect relationships between interventions and observed outcomes, particularly for functional food applications.
Health Canada follows similar principles but maintains unique requirements for natural health products. Its framework requires comprehensive safety assessments and quality control measures aligned with Good Manufacturing Practices (GMP). The regulatory pathway depends on whether the testing supports therapeutic claims or general health-maintenance purposes.
How do FDA requirements differ for microbiome therapeutics versus functional foods?
FDA requirements create distinct regulatory pathways for microbiome-based drugs versus functional foods and dietary supplements. Therapeutic products require Investigational New Drug (IND) applications and extensive clinical trials, while functional foods follow GRAS (Generally Recognized as Safe) notification processes with less stringent requirements.
Microbiome therapeutics classified as drugs must demonstrate safety and efficacy through Phase I, II, and III clinical trials. The FDA requires comprehensive preclinical data showing mechanism of action, dose-response relationships, and safety profiles. Companies must submit detailed manufacturing information, quality control procedures, and risk assessment data as part of their regulatory submissions.
Functional foods and dietary supplements follow a different pathway through GRAS notifications or new dietary ingredient (NDI) submissions. These products require substantial scientific evidence of safety but do not need to prove therapeutic efficacy. However, any health claims must be substantiated with appropriate clinical evidence that meets FDA standards for truthfulness and non-misleading communication.
The key difference lies in the level of clinical evidence required. Therapeutic products need randomised controlled trials demonstrating clinical efficacy, while functional foods primarily need safety data and substantiation for any health claims made. Both categories require robust preclinical testing, but the depth and scope vary considerably based on intended use and marketing claims.
What documentation is required for microbiome testing in clinical trials?
Clinical trial documentation for microbiome testing requires comprehensive protocol design, analytical validation packages, quality control measures, and data integrity standards. Regulatory agencies expect detailed standard operating procedures (SOPs), validation reports, and chain-of-custody documentation for all sample handling and analysis procedures.
Protocol design documentation must include detailed sampling procedures, storage conditions, analytical methods, and statistical analysis plans. Researchers must specify sample collection timing, preservation methods, and transportation requirements to maintain sample integrity. The protocol should address potential confounding factors such as diet, medications, and lifestyle factors that could influence microbiome composition.
Analytical validation packages require method-validation studies demonstrating the accuracy, precision, specificity, and robustness of testing procedures. Documentation must include linearity studies, limits of detection and quantification, and stability studies for stored samples. Quality control measures need established acceptance criteria and procedures for handling out-of-specification results.
Data integrity standards mandate complete audit trails, electronic signature systems, and backup procedures for all data collection and analysis. Regulatory agencies expect compliance with Good Clinical Practice (GCP) guidelines, including proper documentation of any protocol deviations or amendments. All testing facilities must maintain appropriate accreditation and follow established quality management systems.
Which preclinical testing standards must be met before human trials?
Preclinical testing standards require Good Laboratory Practice (GLP) compliance, validated testing methodologies, comprehensive safety assessments, and mechanistic evidence supporting the proposed intervention. Regulatory agencies expect predictive data that demonstrate biological plausibility before approving human studies.
GLP requirements ensure that preclinical studies follow standardised protocols with proper documentation, quality assurance, and data integrity measures. Testing facilities must maintain appropriate accreditation and undergo regular inspections. All personnel involved in testing must receive proper training and demonstrate competency in their assigned tasks.
Validated testing methodologies must demonstrate clinical predictivity through published validation studies showing correlation between preclinical results and human outcomes. The testing system must preserve the original microbiome composition throughout the study period, confirmed through no-substrate controls that demonstrate microbial community stability. Modern regulatory frameworks, such as the FDA Modernization Act 2.0, actively promote non-animal approaches, making validated ex vivo technologies increasingly important.
Safety assessments require comprehensive toxicology studies, dose-response evaluations, and identification of potential adverse effects. Companies must provide mechanistic evidence explaining how their intervention affects gut microbiome composition and function. This includes demonstrating the immediate microbial responses that occur within 24-48 hours of exposure, which serve as foundational events driving longer-term clinical outcomes.
How does Cryptobiotix help with regulatory compliance for gut microbiome testing?
We provide comprehensive regulatory support through our validated SIFR technology platform, which generates the predictive data and mechanistic evidence required for regulatory submissions. Our ex vivo testing methodologies meet the stringent standards expected by regulatory agencies while significantly reducing development timelines and costs.
Our regulatory compliance support includes:
- Validated methodologies with published evidence demonstrating clinical predictivity for taxonomy, metabolomics, and tolerability outcomes
- GLP-compliant testing protocols with comprehensive documentation packages suitable for regulatory submissions
- Mechanistic evidence generation showing mode-of-action data that regulatory bodies require for health-claim substantiation
- Statistical analysis of inter-individual variability using a minimum of 6-8 donors per cohort to identify responder profiles
- Integration with host-microbiome interaction models to demonstrate biological plausibility
Our scientific publications provide the validation evidence that regulatory agencies expect from preclinical testing platforms. We help companies navigate the complex regulatory landscape by providing predictive insights that de-risk clinical trials and support successful product development across multiple applications.
Ready to ensure your gut microbiome testing meets regulatory standards? Contact our team to discuss how our validated SIFR technology can support your regulatory compliance needs and accelerate your product development timeline.
Frequently Asked Questions
How long does the regulatory approval process typically take for microbiome testing platforms?
The timeline varies significantly based on the intended use and regulatory pathway. Research-grade testing platforms can often be implemented within 6-12 months with proper documentation, while clinical diagnostic applications requiring FDA clearance may take 2-3 years. Therapeutic applications following the IND pathway typically require 3-5 years for full approval, depending on the complexity of clinical trials required.
What are the most common regulatory compliance mistakes companies make when developing microbiome tests?
The most frequent mistakes include inadequate analytical validation documentation, insufficient mechanistic evidence for health claims, and failure to establish proper chain-of-custody procedures for sample handling. Many companies also underestimate the importance of demonstrating clinical predictivity in preclinical studies and fail to account for inter-individual variability in their statistical analysis plans.
Can the same microbiome testing data be used for regulatory submissions across different jurisdictions?
While core analytical and safety data can often be shared across jurisdictions, each regulatory body has specific requirements that may necessitate additional studies or documentation. For example, EFSA places greater emphasis on mechanistic evidence for health claims, while Health Canada has unique requirements for natural health products. It's advisable to design studies that can meet multiple regulatory frameworks from the outset.
What specific quality control measures are required for microbiome sample collection and storage?
Regulatory agencies require standardized collection protocols with validated preservation methods, temperature-controlled storage with continuous monitoring, and documented chain-of-custody procedures. Quality control measures must include stability studies demonstrating sample integrity over time, contamination prevention protocols, and established acceptance criteria for sample quality assessment before analysis.
How do I determine which regulatory pathway is appropriate for my microbiome-based product?
The appropriate pathway depends on your product's intended use, target population, and marketing claims. Products making therapeutic claims require drug development pathways (IND/NDA), while general wellness products may qualify for dietary supplement regulations. Consult with regulatory experts early in development to assess your specific situation, as pathway selection significantly impacts development timelines, costs, and evidence requirements.